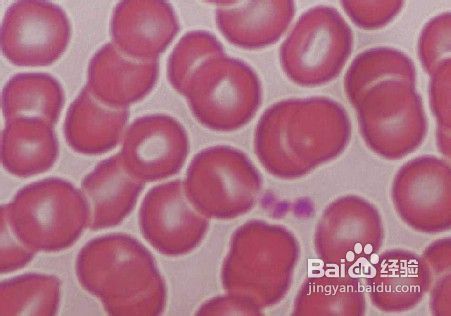
继发性血小板增多症发病机制

继发性血小板增多症发病机制
1、 1、继发性血小板增多症的血小板增多大多数是由于血小板生成加速所致。

2、2、血小板寿命正常或降低。血小板功能试验包括各种诱导剂诱导的血小板聚集,血小板第3因子释放和出血时间常正常。
3、 3、血栓形成因血小板数增加引起,可能与发生在血管内的大量血小板自发聚集有关。出血因与大量增多血小板的血小板凝血活性异常有关。

4、 4、肾上腺素使血小板从贮存场所释放导致血小板增多,无脾者血小板数不增高表明主要从脾释放。运动也使血小板释放而血小板增多,但无脾者也发现运动后血小板增多。

声明:本网站引用、摘录或转载内容仅供网站访问者交流或参考,不代表本站立场,如存在版权或非法内容,请联系站长删除,联系邮箱:site.kefu@qq.com。
阅读量:158
阅读量:168
阅读量:70
阅读量:146
阅读量:75